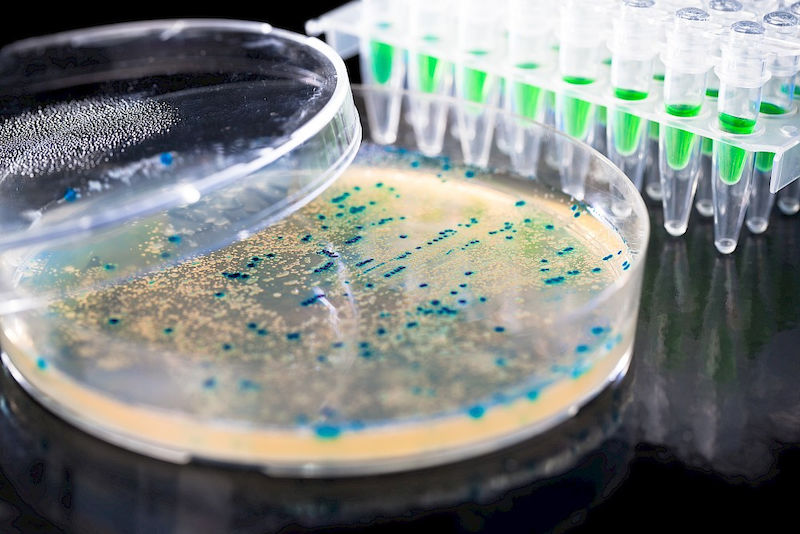

Die Geheimnisse der Gerste
Prof. Dr. Nils Stein erforscht die Genome wichtiger Getreidearten. Seit Oktober ist er gemeinsamer Professor für „Kulturpflanzengenetik“ an der MLU und dem Leibniz-Institut für Pflanzengenetik und Kulturpflanzenforschung (IPK) in Gatersleben. Mit der Berufung ist die Leitung der Abteilung „Genbank“ des IPK verbunden. Artikel lesen